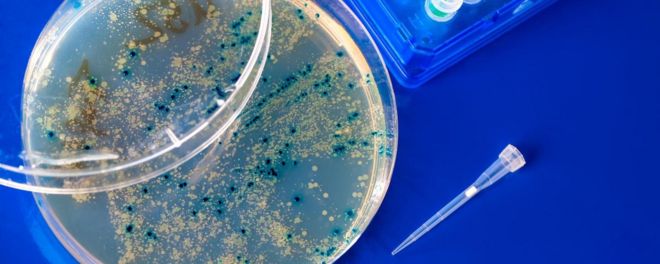
細菌

【我們為什麼挑選這篇文章】「中華民族」成為近代中國人團結國家的重要口號,但是縱觀中國歷史,整個「中華民族」其實被外族滅絕了好幾次。真正的「漢文明」早在唐朝就已經不純粹、在宋朝就走樣、到清朝根本看不懂了,所謂「中華民族」根本就是一個騙局,因為從來不存在這樣一個民族。(責任編輯:蔡沛宇)

文/ 周布雅
武王伐紂周朝取代商朝,周朝就是蠻族,如果以中原文化做為中國的定義,中原文化正統傳承的商朝被周朝滅掉,炎黃文明就已經覆滅了,而且周朝對商文明實施非常徹底的文明滅絕,從語言到文字到信仰到祭祀到圖騰神明,實施徹底的毀滅,嚴格說炎黃文明到周朝已經毀滅了。

秦滅六國,周文明又被滅絕一次,書同文車同軌並且上到祭祀禮儀下到婚喪喜慶的禮俗全部按照秦法,這不就是又一次的強迫放棄文化嗎?可是,春秋時期秦人還被中原諸國視為蠻族阿!
秦國可不是透過中原人傳送過去突然冒出來在那裏,而是本來就存在,無論血緣、文字、語言、信仰、婚喪喜慶的禮俗都與中原人完全不同的民族,而且連中原人都當他們是蠻族看,只是後來秦人接受周人的冊封之後,被視為廣義的周朝人而已,所以當大秦建立,滅亡炎黃文明的周文明又被關中文明毀滅了。
廣告
漢朝是楚國人建立的,可是直到戰國,楚人也是無論血緣語言文字風俗信仰禮俗都跟中原人完全不同的民族,楚人喜歡在臉上刺青,可是在其他中原國家臉上刺青是一種羞辱性的刑事懲罰,連服裝的文化都徹底的不同。打個比方,就跟清朝時期的台灣漢人與原住民之間的差異那麼大。
在當時無論如何你也不可能把周人跟楚人當成同一個民族,秦國還屬於比周人落後的文明,因此在學術、服裝、實用技術等等被周人同化很嚴重,但是楚人是文明程度不弱於周人的強大民族,因此維持了本位文化很久的時間,在被秦滅亡後抵抗也特別激烈。
不過話說回來,漢朝幾乎完全繼承了秦制,甚至楚集團的皇家跟貴族群最後也放棄了楚文化被同化了,因此漢朝嚴格說不能說是外族統治的,就像金被宋同化了甚至自認為是漢人,因此嚴格說漢族還是主導地位的。
廣告
可是清就真的是被外族統治了,漢朝嚴格說我們不能說是外族,但是也有別於純粹的秦文明而融合了南方的文化,因此應該獨立稱作漢文明,此時更早的周文明與商文明已經徹底滅絕,連山海經中屬於商周時期的圖騰眾神都已經被遺忘,漢朝建立屬於自己獨有的新文明。
唐朝的關中集團就真的是外族,而且也把外族的文明帶進了中原(當時稱作胡風),這時候漢文明不能說已經斷絕,但是已經被強迫與異族文明融合,成為有別於漢文明的新文明。

簡單的解釋就是,如果你穿越到漢朝跟唐朝各抓一個人來比較,你絕對不可能認為兩人屬於同一個民族,因為無論服裝風格、生活習俗、禮儀、音樂、祭祖的方式到信仰的神明都有很大的差異,這已經是一個融合了外族文明與漢文明的新文明了。
日本後來從中國學走的和服唐禮漢字等等,就是屬於唐文明,所以很多漢字,用日文發音反而比中文發音更加正統,有些文字的意義中文經過變遷意義已經與古代不同,反而日文保留最原本的解釋,因為他們學的漢字有很大部分是直接對接唐字的(當然後代還有持續輸入,不過唐字比重最高)。

宋朝是個很有趣的國家,宋朝文化上面追求漢文明的純化,基於夷夏之防的觀念『導正』了唐文明很多受到蠻族『汙染』的文化,從這時候開始,仿唐的日本漢學就開始跟中國漢學越走越遠了,因為宋人認為唐朝的文化其實並不正統。
可是日本人覺得他們自唐朝學到的漢學才最正統,此後兩方的漢學就開始有越來越多的差異,當然我們比較宋朝的文明跟唐朝的文明,從服裝、語言、民俗禮樂、文化祭典到信仰,又可以發現極大的差異,因為追求儒學純粹化的宋朝,刻意把唐朝受到異文明影響的部分努力剔除了,嚴格說這還不能說是不一樣的一個文明,可是也是一個大幅度自我蛻變的文明
元朝根本上根本不能視為一個中國王朝,它只是大蒙古帝國分署的一個殖民地屬國而已,一個中國王朝會把人民公民權分成四等,然後漢人被定義成最低賤的一等嗎?元朝根本上就不是一個國家,而是蒙古人的一個殖民地而已,而且蒙古人也沒有漢人意淫的『被同化』,自始至終他們都保有自己的服飾、語言、習俗跟信仰。
這點清朝也是相同,清朝皇帝正式的職稱是,漢地十八省、蒙古、西藏,以及關外的共主,四地之間是互不統屬的,中原領土只是滿族皇帝的殖民地之一而已,滿族始終認為他們真正的領土是關外,這有無數文書為證。
至於滿族人被同化是民國以後,是滿族人接受了五族共和建立新國家,自己自願被漢人同化的,在此之前滿族始終堅持滿族人要學習自己的文明,終整個清朝,中國領土都只是滿族人的殖民地,根本不能視為漢文明王朝,連頭都剃了留辮子了,民國建立以後還哭著不剃辮子了還漢人?已經完全被殖民化了!

從上到下算下來,整個『炎黃民族』已經被外族滅亡幾次了?甚至,已經下到語言上到對祖先的祭祀與信仰的神明都被替換掉幾次了?
我不反對文化上自認是華人拉,我自己就經常講文化上我自己都自認是華人,可是華人更要認清歷史,沒有『炎黃民族』也沒有『華夏民族』這回事,炎黃民族亡於周,中國的文明經過多次的異族征服跟文明滅絕,根本沒有所謂『五千年傳承』這回事。
所謂『中華文明』其實並非漢人獨有,而是眾多文明共同建立、共同分享的,在每個時代漢文明都不停變化,因為在每個時代漢文明都吸收了其他的民族納入。
真正的漢文明在唐朝就已經不純粹、在宋朝就走樣、到清朝根本看不懂了,中華文明是眾多異族跟漢族共同打造分享的結果,甚至應該說,所謂『中華民族』根本就是一個騙局,因為從來不存在這樣一個民族,所謂用中文就是中國人自然也就無從說起了。